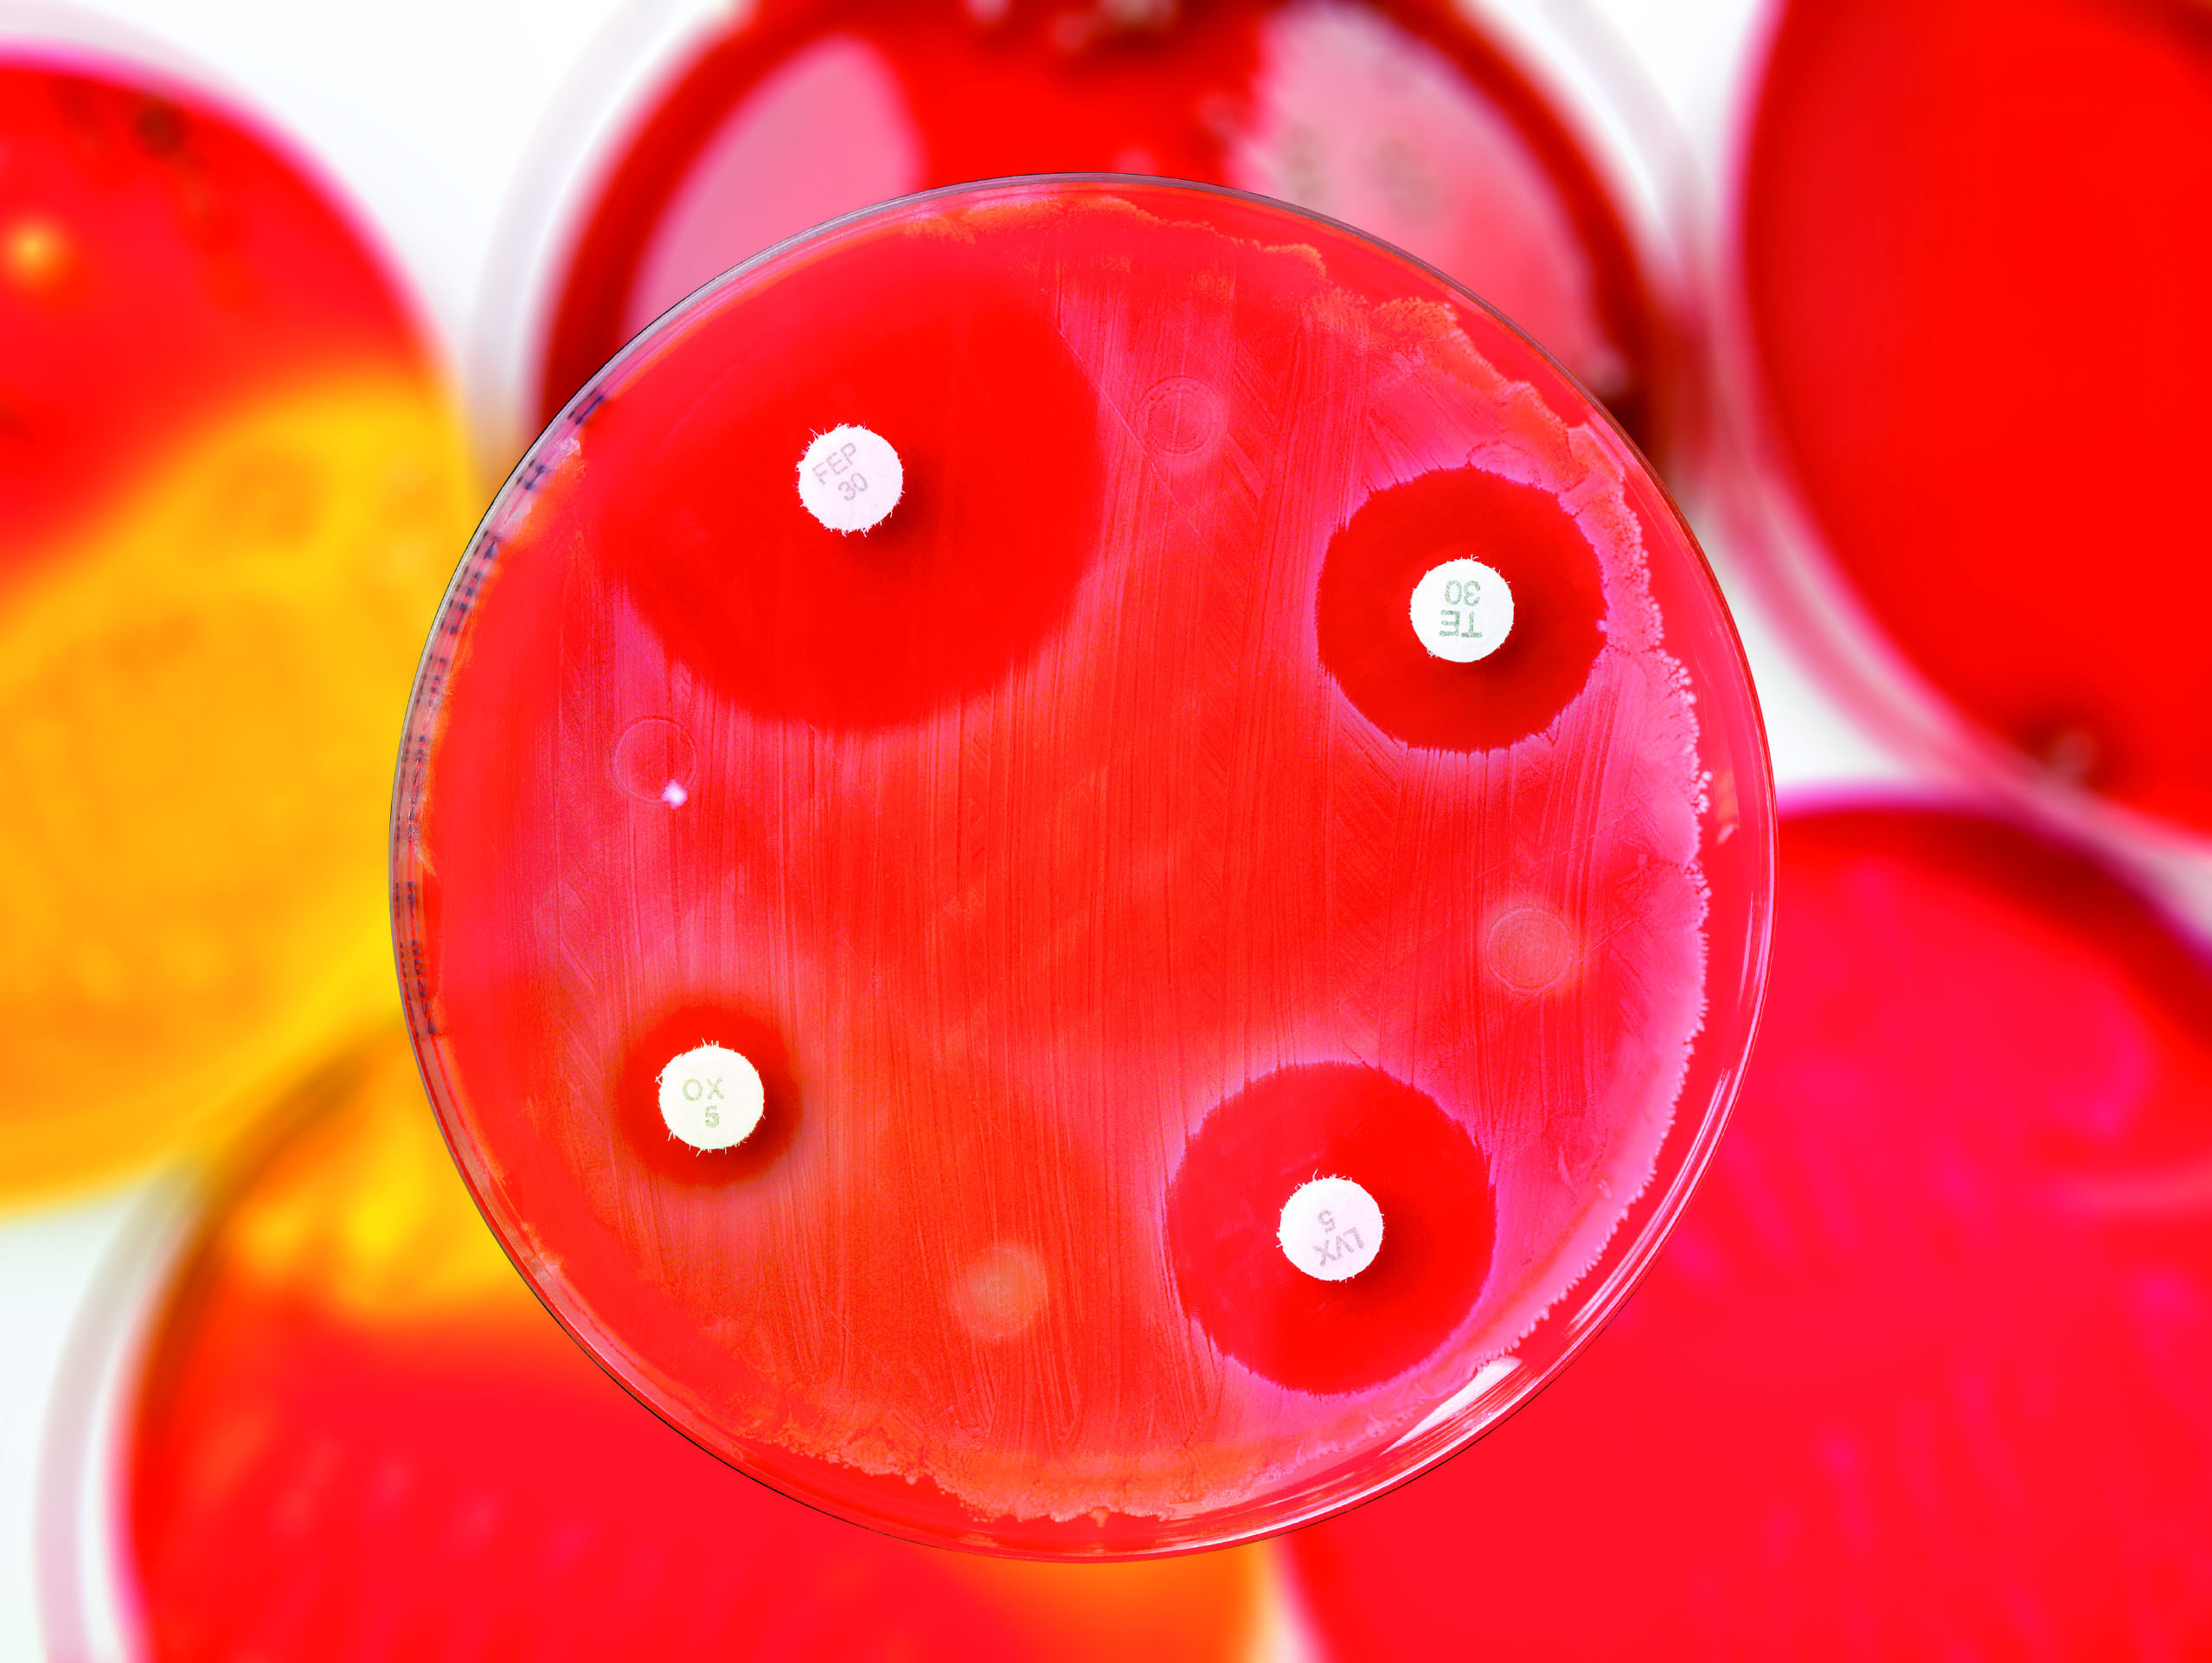
Røde dyrkningsskåler for bakterier med antibiotikatabletter

NORM-rapporten for 2024 er publisert
Foto: ECDC
I Norge er forekomsten av antibiotikaresistens fortsatt lav i bakterier fra mennesker og dyr. Dette skyldes lavt forbruk av antibiotika, et fordelaktig forbruksmønster, og effektive tiltak mot spredning av resistente bakterier.
Rapporten fra NORM og NORM-VET inneholder data for forekomst av antibiotikaresistens og forbruk av antibiotika hos mennesker og dyr, og i mat. Rapporten inneholder også aktuelle artikler om utvalgte tema, deriblant en artikkel om antibiotikaprofylakse ved kirurgi.
Rapporten med data til og med 2024 er nå tilgjengelig her: NORM og NORM-vet 2024
NORM og NORM-VET ble etablert som deler av regjeringens tiltaksplan mot antibiotikaresistens, offentliggjort i 2000, og har 25-årsjubileum i 2025. Bakteppet for opprettelsen av NORM og NORM-VET var 80- og 90-tallets bekymringsfulle økning av antibiotikaresistens rundt om i verden.
Les mer her: NORM - Norsk overvåkingssystem for antibiotikaresistens hos mikrober